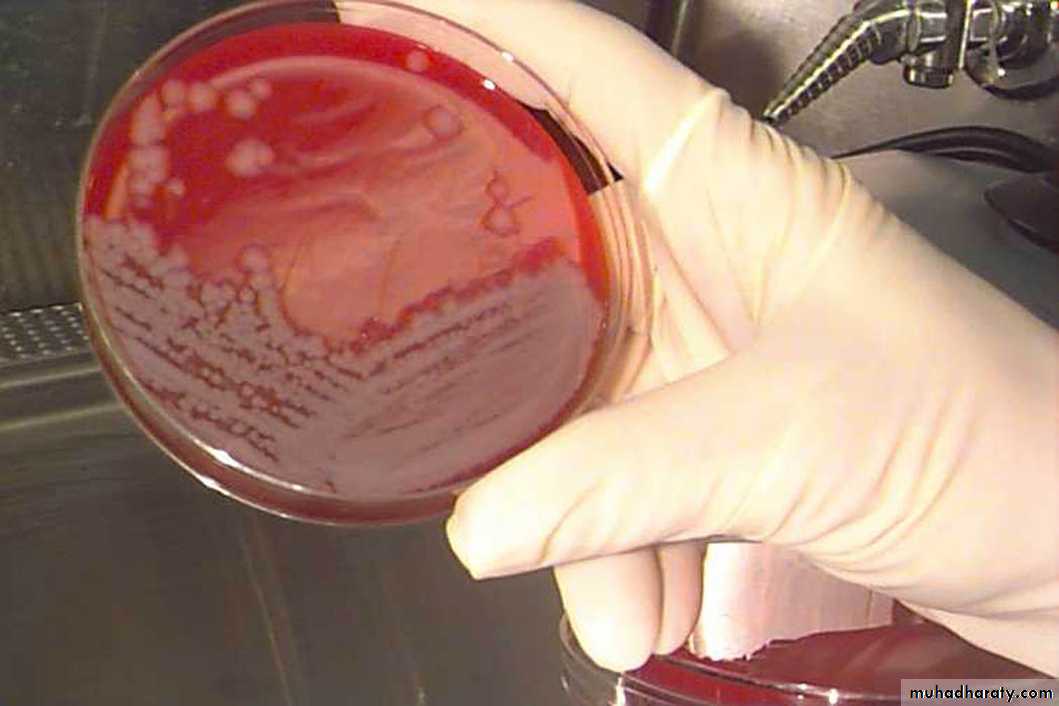
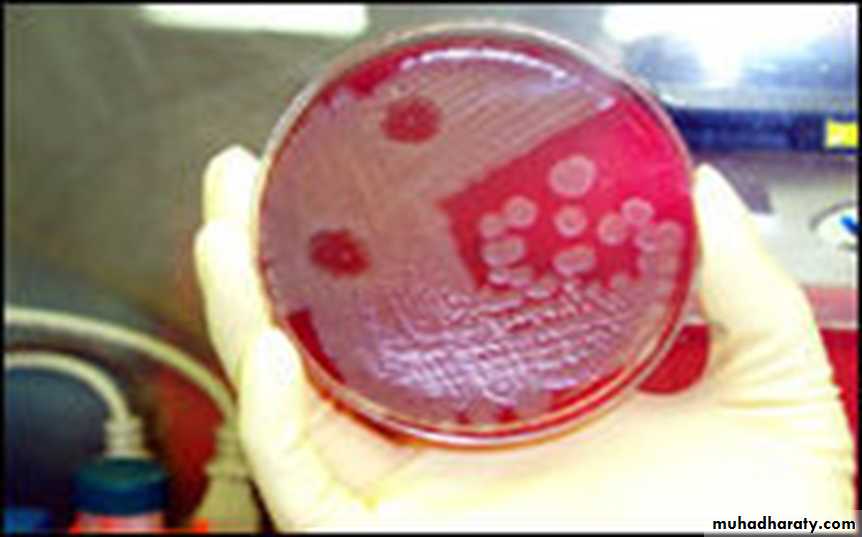
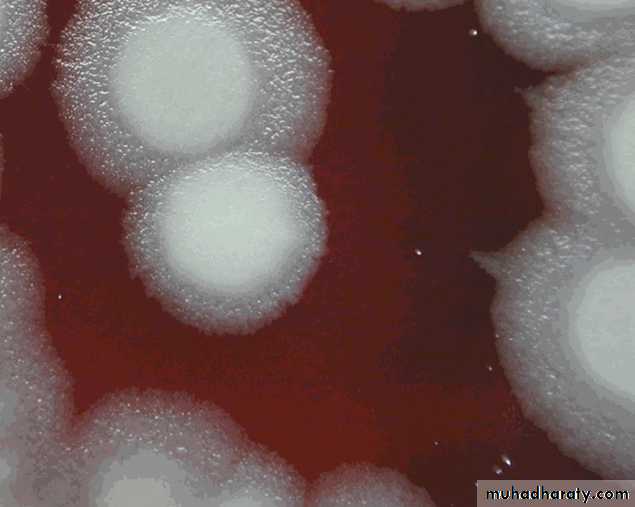
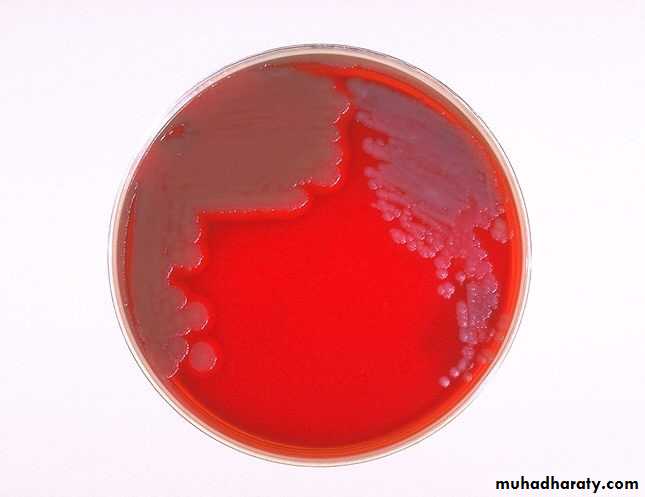
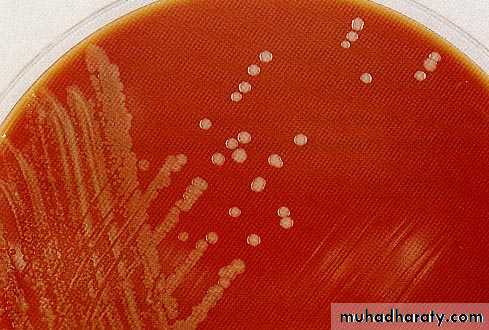

Oral Micobiology
3rd YearSpore Forming Rods
Bacillus
gram-positive spore-forming rods, Bacillus and
Clostridium.Bacillus and Clostridium cause disease by the release
of potent exotoxins .They differ biochemically by their like or dislike of oxygen.
Bacillus enjoys oxygen (so is aerobic),
while
Clostridium multiply in an anaerobic environment.
Bacillus anthracis
The genus Bacillus comprises nearly50 species of
B.anthracis
a-sporing, spore located in the center of bacilli
b-Gram-positive,
C- arranged in long chain(chain -forming bacilli.
D- non motile bacilli
Most are soil saprophytes. Two species,
Bacillus anthracis and Bacillus cereus,
cause signifcant morbidity
Bacillus anthracis causes the disease anthrax
Bacillus cereus causes gastroenteritis(food poisoning).Culture &Growth characteristic
Colonies of B.anthracis are round andhave a “cut glass” apperane in
transmitted light.
Hemolysis in uncommon with
B.anthracisbut common with B.cereus
and the saprophytic bacilli .
Gelatin liquefied, and
growth in gelatin stabsresembles an inverted fir tree
SELECTIVE MEDIA – PLET MEDIUM –POLYMYXIN, LYSOZYME, EDTA & THALLOUS ACETATE
Gelatin liquefied, and
growth in gelatin stabsresembles an inverted
fir tree
Bacillus anthracis
Spores of B. anthracis can survive in soil for years.Humans are accidental hosts, and infection (anthrax) is acquired when spores enter abrasions on the skin or are inhaled.
Infection causes septicaemia and death; pulmonary anthrax
(woolsorters’ disease) is a life-threatening pneumonia causedby inhalation of spores.
The polyglutamic acid capsule of the
organism is antiphagocytic.
The anthrax spores used in
biological warfare and bioterrorism
Portal of entry
Its an Accidental infection Secondarily infected from diseased animalIn human the infection acquired by entry of spors through
1- Mouth and the gastrointestinal tract called (gastointestinal anthrax ).
2- SkinHumans are exposed to the spores during direct contact with infected animals or soil, or when handling infected animal products, such as hides or wool through injured skin (cutaneous anthrax).3-Respiratory trat by inhalation of spores into lung
(inhalation anthrax )***** Human-to human transmission has never
been reportedThis figure demonstrates how the Bacillus anthracis spores are contracted from contaminated products made of hides and goat hair.
The spores can germinate on
1- skin abrasions (cutaneous anthrax),
be 2- inspired into the lungs (respiratory anthrax),
or 3-ingested into the gastrointestinal tract (GI anthrax).
The spores are often phagocytosed by macrophages in the skin, intestine, or lung and then germinate, becoming active (vegetative) gram-positive rods. The bacteria are
released from the macrophage, reproduce in the lymphatic system, and then invade the bloodstream
CUTANEOUS ANTHRAX
Spores enter thro’ abraded skinGerminate & Multiply at the site of entry.
Localised lesions - Face, neck & hand.
Papule – vesicle – pustular – centrally necrosed – black coloration.
Pulmonary anthrax
After invading blood circulation release of exotoxin is the major reason why anthrax carries such a high mortality rate. These toxins are encoded on a plasmid.The exotoxin contains 3 separate proteins, which by themselves are nontoxic
but together producethe systemic effects
of anthrax:
FactorI – Edema factor EF
FactorII–Protective factor PF
FactorIII–Lethal factor LF
Bacillus cereus
B. cereus causes food poisoning, especially when reheated, contaminated rice is eaten (particularly in restaurants serving rice-based dishes)Physiology and Pathogenesis
Bacillus cereus food poisoning:Large, motile, saprophytic bacillus
Heat resistant spores
No capsule
Pre formed heat and acid stable toxin (Emetic syndrome)
Heat labile enterotoxin (Diarrhoeal disease)
Lab diagnosis – Demonstration of large number of bacilli in food
Bacillus cereus
Monday, March 13, 2017
Physiology and Pathogenesis
Bacillus cereus food poisoning:• Bacillus cereus causes two types of food-borne intoxications.
• Emetic Form:- Characterized by nausea and vomiting and abdominal cramps and has an incubation period of 1 to 6 hours. - Resembles Staphylococcus aureus food poisoning in its symptoms and incubation period (short).
• Diarrheal Form: - Manifested primarily by abdominal cramps and diarrhea with an incubation period of 8 to 16 hours. - Diarrhea may be a small volume or profuse and watery.- It resembles more food poisoning caused by Clostridium perfringens.
Monday, March 13, 2017
Physiology and Pathogenesis
Bacillus cereus food poisoning:Lab Diagnosis (comparative)
Monday, March 13, 2017
Physiology and Pathogenesis
Bacillus cereus food poisoning:Lab Diagnosis (comparative)
Colonies of Bacillus anthracis (right) and Bacillus cereus (left) on a plate of blood agar. CDC.
Monday, March 13, 2017
Bacillus stearothermophilus andBacillus subtilis
These are used as biological indicators to test the sterilization effcacy of autoclaves, ethylene oxide and ionizing radiation.Neisseriaceae,
The Neisseriaceae include the genera Neisseria and Moraxella.Two species of Neisseria are human pathogens:• Neisseria gonorrhoeae (the gonococcus)• Neisseria meningitidis (the meningococcus).There are a number of non-pathogenic species, such as Neisseria sicca, Neisseria mucosa and Neisseria lactamica, which are members of the indigenous flora, including the oral mucosa.Hence, it is important to differentiate these from the pathogenic species from oral samples.
N. gonorrhoeae is the agent of gonorrhoea, the most frequently diagnosed venereal disease in western Europe and the USA.
Gonococci frequently cause pelvic inflammatory
disease (PID) and sterility in women, in addition to arthritis and sometimes septicaemia.N. meningitidis is the aetiological agent of meningococcal meningitis, a highly contagious disease associated with a mortality rate approximating 80%
when untreated
Important difference between n.gonorrhoeae & n. meningitidis
N. gonrrhoeae N. meningitidis
Note:both can be differentiated by biochemical tests using serum sugar
I have got an antibiotic resistant plasmidI have got a polysaccharide capsule
N. gonrrhoeae General characteristics
Non-motile, Gram-negative cocci ranging from 0.6 to 1.0 µmin diameter.On microscopy, the cocci are seen as pairs with concave adjacent sides (bean-shaped); tetrads, short chains and clusters are occasionally seen but all show the characteristic pairing.
Pathogenic Neisseria species are nutritionally fastidious, especially on initial isolation from clinical specimens; the non-pathogenic species are less so.
although aerobic, most strains of N. gonorrhoeae are capnophilic (they require increased carbon dioxide for growth); haemolysed bloodand solubilized starch enhance growth.
Members of this genus grow optimally at 36–39°C,although the non-pathogenic species can grow at temperatures below 24°C.
Neisseria gonorrhoeae in Urethral Exudates
Neisseria gonorrhoeaeHabitat and transmissionThe human urogenital tract is the usual habitat; oral, nasopharyngeal and rectal carriage in healthy individuals isnot uncommon.
Spread is by both homosexual and heterosexual intercourse or intimate contact.
Characteristics
Non-motile, Gram-negative, non-capsulate diplococci.Culture and identifcationSpecimens are usually inoculated onto an enriched medium(lysed blood or chocolate agar normally) and incubatedunder 5–10% carbon dioxide (as the species is capnophilic).Small, grey, oxidase-positive colonies initially become largeand opaque on prolonged incubation.
Subsequent staining by fluorescent antibody techniques, and the production of acid from glucose but not from maltose or sucrose, confrms the identifcation.
Gram-stained smears (of urethral exudate from men and the cervix in women) usually reveal Gram negative, kidney-shaped intracellular cocci in pairs
Colony morphology: Colonies are
smallround
translucent
convex or slightly umbonate
finely granular surface
lobate margins.
Pathogenicity
Gonococci possess a number of virulent attributes:• pili allow gonococci to adhere and colonize epithelialsurfaces and thus cause infection• immunoglobulin A (IgA) proteases produced by somegonococci break the heavy chain of IgA, therebyinactivating it (IgA is a major defence factor universallypresent on mucosal surfaces)
• some isolates of N. gonorrhoeae produce β-lactamase,which is plasmid-mediated
• a outer membrane OMP lead to pore formation and invade the infected tissue also its respsible of robs from host immuve by Ag variability character
Mechanism of pathogenesis:
Gonococci adhere to epithelial cells of urethra or
other mucosal surface through pilipenetrate through the intercellular space
reach the sub epithelial connective tissue &causes inflammation
Leads to clinical manifestations
Incubation period: 2-8 days.• Disease:
• A) In men:• The disease starts as an acute urethritis with a
• mucopurulent discharge
• extends to the prostate, seminal
• vesicles & epididymis
• In some it may become chronic urethritis
• The infection may spread to the periurethral tissues,
• causing abscesses & multiple discharging sinuses
• (Watercan perineum)
B) In women:
The initial infection is urethritis & cervicitis but vaginitis
does not occur in adult female (vulvovaginitis canoccur in prepubertal girls)
The infection may extend to Bartholin’s glands,
endometrium & fallopian tubes causingPelvic Inflammatory Disease (PID)
Rarely peritonitis may develop with perihepatic
inflammationC) In both the sexes:
Proctitis, pharyngitis,conjunctivitis, bacteraemia which may lead to
metastatic infection such as arthritis,
endocarditis, meningitis, pyemia & skin rashes.
D) In neonates:
Opthalmia neonatorum (anonvenereal gonococcal conjunctivitis in the
newborn) results from direct infection during
passage through birth canal.
• Treatment and prevention
The majority of gonococci are resistant to β-lactam drugs and hence the choice is β-lactamase-stable cephalosporins.
Prevention of gonorrhoea requires the practice of ‘safe sex’, health education and contact tracing
Neisseria meningitidis
MorphologyShape of Neisseria meningitidis
Described and isolated by weichselbaum from spinal fluid of patient,1887Habitat and transmission
The main reservoir is the nasopharynx in healthy individuals(10–25%).Droplet spread is the most common transmission mode.
CharacteristicsThis organism resembles the gonococcus but N.meningitidiscells are capsulate.
Culture and identifcationr N. meningitidis dentifcation is made by observing Gram-negative cocci in pairs in nasopharyngealdischarge, cerebrospinal fluid or blood smears.
Selectivemedia are not required as the organism is found pure in cerebrospinal fluid.
Identifed by the carbohydrate utilization test: produces acid from the oxidation of glucose and maltose.
Serology is useful Based on the outermembrane protein serogroups further divided into serotypes About 20 serotypes have been identified
Biochemical tests
Biochemical testsVirulence Factors
Fimbrae (common pili)-Lipooligosaccharide:
CapsuleCell membrane proteins
IgA protease-Pathogenesis (Steps)
Pathogenesis (steps)Pathogenicity
In susceptible individuals, meningococci spread from the nasopharynx into the blood stream (septicaemia), and then to the meninges.
Septicaemia is accompanied by a rash.
Eventual death may be due to meningitis or adrenal haemorrhage .The antiphagocytic properties of the capsule help dissemination, while the toxic effects are mainly due to the meningococcal endotoxin.
Hemorrhage in the adrenal glands in Waterhouse-Fridericksen syndrome
Meningococcal disease is favoured by defieciency of the terminal complement components (C5-C9)Treatment and prevention
Penicillin or cefotaxime (or equivalent cephalosporin).Commensal Neisseria speciesCommensal Neisseria species are common in the oral cavity, nose and pharynx, and sometimes in the female genital tract.
The three main species are
Neisseria subflava, N. mucosa
and N. sicca.
The main difference between these and the pathogenic Neisseria species is the ability of the commensal species to grow on ordinary agar at room temperature in the absence of carbon dioxide supplements.
These organisms are essentially non-pathogenic and are almost always found in oral specimens
contaminated with saliva or mucosa.
Neisseria species are among the earliest colonizers of a clean tooth surface.
They consume oxygen during the early plaque formation and facilitate subsequent growth of facultative and obligate anaerobic late colonizers.Moraxella
Moraxella (formerly Branhamella) are Gram-negative cocci closely related to the non-pathogenic Neisseria species, but asaccharolytic and non-pigmented.They are commensals of the human respiratory tract and are recognized opportunistic pathogens causing meningitis, endocarditis, otitis media, maxillary sinusitis and chronic obstructive pulmonary disease.
As the majority of strains produce β-lactamase, theymay indirectly ‘protect’ other pathogens and thus complicate antibiotic therapy.